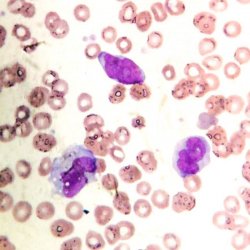

Blog HemoClass
Blog HemoClass

MACROPLAQUETAS E COVID-19
Warning: strtotime(): It is not safe to rely on the system's timezone settings. You are *required* to use the date.timezone setting or the date_default_timezone_set() function. In case you used any of those methods and you are still getting this warning, you most likely misspelled the timezone identifier. We selected the timezone 'UTC' for now, but please set date.timezone to select your timezone. in /home/hemocla/public_html/site/blog.php on line 179
Warning: date(): It is not safe to rely on the system's timezone settings. You are *required* to use the date.timezone setting or the date_default_timezone_set() function. In case you used any of those methods and you are still getting this warning, you most likely misspelled the timezone identifier. We selected the timezone 'UTC' for now, but please set date.timezone to select your timezone. in /home/hemocla/public_html/site/blog.php on line 179
14/04/2021 |
 #Hemostasia e Coagulação
#Sindromes
#Coagulograma
#exames
#Hemostasia e Coagulação
#Sindromes
#Coagulograma
#exames
Diariamente recebo questionamentos de nossos assessorados sobre a presença de macroplaquetas em pacientes com COVID-19. Será que há relação?
Vejamos:
Dentre várias complicações relatadas em pacientes com SARS-CoV-2 (insuficiência cardíaca, síndrome coronária aguda, insuficiência renal, etc...), estão os estados de hipercoagulabilidade.
A infeção pelo SARS-CoV-2 envolve intensa resposta inflamatória, com estado de hipercoagulabilidade e isquemia, agravados por hipoximia, de forma que o processo inflamatório instalado resulta na lesão endotelial com consequente ativação da produção de fibrina e redução da fibrinólise, o que caracteriza o estado pró-trombótico, que muitas vezes evolui para Coagulação Intravascular Disseminada (CIVD). Os elementos principais que levam à esse quadro são as citocinas inflamatórias, entretanto outros componentes estão envolvidos.
São basicamente três vias anticoagulantes fisiológicas que sofrem disfunção na sepse: o sistema antitrombina, o sistema de clareamento de fatores pela proteína C e o inibidor da via do fator tecidual. Também o sistema fibrinolítico sofre uma redução drástica, o que faz a “balança da hemostasia” ter o seu fiel deslocado para o lado da hipercoagulação.
A hemostasia primária (plaquetas) também é ativada pelo processo, refletindo em uma mudança morfológica das plaquetas.
Tanto as macroplaquetas quanto as plaquetas gigantes refletem um quadro de ativação plaquetária como estados trombóticos ou pré-trombóticos de uma maneira geral. É importante salientar que as plaquetas maiores são mais propensas à agregação, sendo fator de risco para trombose, se ela já não estiver acontecendo.
Macroplaquetas exibem um tamanho entre uma plaqueta normal e uma hemácia. Devem ser relatadas quando encontradas em uma quantidade igual ou maior que 5% das plaquetas analisadas, já as plaquetas gigantes tem um tamanho maior que a hemácia. Assim como as macroplaquetas, devem ser relatadas, se presentes, mesmo em baixa quantidade.
Para alguns autores relatam a presença de plaquetas gigantes como metamorfose viscosa, e tanto as plaquetas gigantes quanto as macroplaquetas, revelam um quadro de ativação plaquetária, e deve ser relatado no hemograma.
Resumindo:
1) A SARS-CoV-2 desencadeia, por meio de citocinas inflamatórias e outros mecanismos, a cascata da coagulação e a agregação plaquetária.
2) As plaquetas, quando ativadas, modificam a sua morfologia e aumentam de tamanho, formando as macroplaquetas e plaquetas gigantes.
3) Essas macloplaquetas e plaquetas gigantes refletem à quadros pró-trombóticos, ou seja, são fatores de risco para trombose, CIVD, e outras complicações hemostáticas.
4) É extremamente importante que se relate a presença de macroplaquetas e plaquetas gigantes, quando presentes, no hemograma de pacientes suspeitos ou confirmados para COVID-19.

Agregação Plaquetária
Warning: strtotime(): It is not safe to rely on the system's timezone settings. You are *required* to use the date.timezone setting or the date_default_timezone_set() function. In case you used any of those methods and you are still getting this warning, you most likely misspelled the timezone identifier. We selected the timezone 'UTC' for now, but please set date.timezone to select your timezone. in /home/hemocla/public_html/site/blog.php on line 179
Warning: date(): It is not safe to rely on the system's timezone settings. You are *required* to use the date.timezone setting or the date_default_timezone_set() function. In case you used any of those methods and you are still getting this warning, you most likely misspelled the timezone identifier. We selected the timezone 'UTC' for now, but please set date.timezone to select your timezone. in /home/hemocla/public_html/site/blog.php on line 179
17/03/2021 |
 #Hemostasia e Coagulação
#Coagulograma
#Hemostasia e Coagulação
#Coagulograma
Um problema frequente no laboratório e a agregação plaquetária. Esse fato pode diminuir a contagem das plaquetas causando uma falsa trombocitopenia.
Entretanto é preciso saber se realmente é uma trombocitopenia ou se trata mesmo de agregação plaquetária, e a lâmina é fundamental para essa verificação.
Existem algumas alternativas para contornar esse problema.
Primeiro: a lâmina foi feita na hora da coleta? Uma lamina na hora da coleta com agregação significa que essa agregação é do paciente e não artefato, então é algo a se relatar para o médico!
Caso a agregação seja artefatual recomendamos:
Segundo: Deixe a amostra um tempo no banho maria. Esse tempo não é padronizado. Costuma-se deixar entre 40 – 60 minutos. Passe novamente a amostra no equipamento.
Se a agregação persistir:
Terceiro: se sugere a troca de anticoagulante para citrato, pode resolver. Mas existem casos aonde mesmo no citrato a agregação persiste, e ainda, outros casos que agregam mais no citrato do que no EDTA.
Quarto: Essa alternativa costuma dar sempre um bom resultado, mas você precisa quebrar o padrão, pois precisa coletar do paciente próximo ao equipamento, sem anticoagulante, e passar imediatamente no aparelho.
Quinto: Muitos profissionais utilizam o vortex para dar uma homogeneizada mais violenta na amostra. Eu prefiro deixar essa opção como última, se for possível, pois pode acontecer a fragmentação de hemácias e causar outros interferentes.
Essas são alternativas, listadas na ordem que recomendamos para os laboratórios que participam do programa de assessoria remota da HemoClass.

Descrição do Blasto
Warning: strtotime(): It is not safe to rely on the system's timezone settings. You are *required* to use the date.timezone setting or the date_default_timezone_set() function. In case you used any of those methods and you are still getting this warning, you most likely misspelled the timezone identifier. We selected the timezone 'UTC' for now, but please set date.timezone to select your timezone. in /home/hemocla/public_html/site/blog.php on line 179
Warning: date(): It is not safe to rely on the system's timezone settings. You are *required* to use the date.timezone setting or the date_default_timezone_set() function. In case you used any of those methods and you are still getting this warning, you most likely misspelled the timezone identifier. We selected the timezone 'UTC' for now, but please set date.timezone to select your timezone. in /home/hemocla/public_html/site/blog.php on line 179
23/11/2020 |
 #Leucemia
#Hematoscopia
#Sindromes
#exames
#HemoClass Leucemias
#Leucemia
#Hematoscopia
#Sindromes
#exames
#HemoClass Leucemias
Já, de longa data, batemos na tecla de que um blasto precisa ser contado na diferencial como blasto mesmo. Mas isso não é suficiente! Ele precisa ser descrito!
São várias linhagens possíveis para os blastos, desde blastos mielóides com graus diferentes de maturação, monocitóides, linfoides, etc.... A descrição leva em conta algo fundamental que é dar a ideia do que se esta vendo para um direcionamento diagnóstico mais eficiente e uma imunofenotipagem mais acertiva.
Antigamente a morfologia era deficitária, com colorações ruins, microscópios ruins, e analistas com pouco preparo. Hoje tudo isso evoluiu. Temos bons equipamentos, excelentes combinações de corantes e conhecimento acessível a todos pela internet, independente de onde a pessoa esteja!
Mas como descrever um blasto então? Vamos sugerir alguns passos para que você tenha sucesso com seu hemograma!
1) Tamanho da célula (P, M ou G)
2) Relação Núcleo citoplasma (alta, media ou baixa)
3) Parâmetros nucleares:
a. Contorno regular ou pleomórfico
b. aspecto de cromatina (densa ou frouxa) (homogênea ou heterogênea)
c. Nucléolos (ausentes, visíveis, evidentes ou proeminentes)
4) Paramentros de citoplasma
a. Basofilia (leve, moderada ou acentuada)
b. Inclusões (granulação, B. Auer, C. PHI, etc..)
c. Brotamento ou projeções
5) Alguma característica particular da célula
a. Nucleo em alteres
b. Célula em mitose
c. Célula binucleada
d. agregados celulares
6) Outras características observadas que sejam de importância
Seu hemograma terá outro impacto com uma descrição bem feita, além do que o diagnóstico do paciente tente a ser mais precoce, então comece a treinar sua descrição!
No curso HemoClass Leucemias existe um ponto de extrema importância que são as monitorias. Nelas todos os alunos aprendem e trabalham a descrição dos blastos e os critérios de diferenciação para células imaturas!

65 BASÓFILOS
Warning: strtotime(): It is not safe to rely on the system's timezone settings. You are *required* to use the date.timezone setting or the date_default_timezone_set() function. In case you used any of those methods and you are still getting this warning, you most likely misspelled the timezone identifier. We selected the timezone 'UTC' for now, but please set date.timezone to select your timezone. in /home/hemocla/public_html/site/blog.php on line 179
Warning: date(): It is not safe to rely on the system's timezone settings. You are *required* to use the date.timezone setting or the date_default_timezone_set() function. In case you used any of those methods and you are still getting this warning, you most likely misspelled the timezone identifier. We selected the timezone 'UTC' for now, but please set date.timezone to select your timezone. in /home/hemocla/public_html/site/blog.php on line 179
30/09/2020 |
 #Leucemia
#Leucograma
#Padronização
#exames
#Leucemia
#Leucograma
#Padronização
#exames
Esse caso vem do Laboratório São Lucas - Cáceres - MT, que é assessorado pela HemoClass.
Paciente com diagnóstico de Leucemia Mielóide Crônica, em controle terapêutico com Hidroxiuréia, faz hemograma de acompanhamento:
Eritrograma:
Eri: 3,1 / Hb: 10,9 / VG: 31,1 / VCM: 100 / HCM: 34,8 / CHCM: 34,7 / RDW: 12,7
Leucócitos totais: 49.880
Diferencial automatizado:
Linfócitos: 40 / Basófilos: 10 / Bastonetes: 50 - Flag de Blasto
Plaquetas: 33.000
Ao se analisar a lâmina, porém, a realidade é outra, totalmente diferente!
Muitos basófilos e alguns blastos. Veja nas fotos!
A contagem diferencial ficou bem diferente do aparelho:
Blasto: 1 / Meta: 1 / Bast: 2 / Seg: 15 / Eos: 1 / Linfo: 18 / Mono: 2 / Basófilos: 65
A contagem de basófilos foi revista e confirmada. Embora a LMC costume cursar com basofilia, dificilmente chega a um valor tão alto!
Também não vemos o escalonamento evidente, característico dessa leucemia. Outra situação interessante é a trombocitopenia, já que na LMC o esperado é trombocitose.
A questão do paciente estar em tratamento pode explicar muitos desses índices, mas a contagem de basófilos se relaciona com um prognóstico ruim.
Essa contagem de basófilos foi reportada imediatamente ao médico, que, juntamente com os dados clínicos e monitoramento molecular, vai decidir e adequar a terapêutica.

Análise da lâmina
Warning: strtotime(): It is not safe to rely on the system's timezone settings. You are *required* to use the date.timezone setting or the date_default_timezone_set() function. In case you used any of those methods and you are still getting this warning, you most likely misspelled the timezone identifier. We selected the timezone 'UTC' for now, but please set date.timezone to select your timezone. in /home/hemocla/public_html/site/blog.php on line 179
Warning: date(): It is not safe to rely on the system's timezone settings. You are *required* to use the date.timezone setting or the date_default_timezone_set() function. In case you used any of those methods and you are still getting this warning, you most likely misspelled the timezone identifier. We selected the timezone 'UTC' for now, but please set date.timezone to select your timezone. in /home/hemocla/public_html/site/blog.php on line 179
08/09/2020 |
 #Padronização
#Hematoscopia
#exames
#Padronização
#Hematoscopia
#exames
Um problema verificado de maneira constante em nosso serviço é a análise inadequada da lâmina hematológica. Além de um bom corante (essencial), de evitar artefatos fazendo a lâmina no momento da coleta e de se fazer a hematoscopia em aumento de 100X, o local de análise da lâmina é fundamental para um hemograma confiável.
A lâmina se divide em três partes:
1. Cabeça da lâmina: região imediatamente após o local em que estava a gota sanguínea. Nessa região, com frequência, há aumento do número de leucócitos, com compactação de sua morfologia dificultando a identificação, aglomeração e sobreposição de hemácias.
2. Corpo da lâmina: região intermediária entre cabeça e cauda. É nessa região que os leucócitos, hemácias e plaquetas estão distribuídas de forma mais homogênea. É a área de escolha para a análise qualitativa e quantitativa da distensão sanguínea.
3. Cauda da lâmina: região final da distensão sanguínea. Nessa região acontece uma maior distorção morfológica pelo achatamento. A maioria das alterações de série vermelha aqui encontradas são artefatuais.
A região adequada de se analisar a lâmina é entre o corpo e a cauda (veja foto), aonde as hemácias estão distribuídas lado a lado e é possível enxergar com nitidez o halo central delas.
Sempre que a análise acontece mais para a região da cabeça da lâmina, a tendência é que se encontre rouleaux eritrocitário e aglutinação de hemácias, além de se ter uma compactação dos leucócitos, modificando sua morfologia a ponto de não se conseguir uma identificação satisfatória.
No extremo da cauda, se encontra achatamento das hemácias, o que pode induzir a visualização de dacriócitos, esferócitos e algumas outras formas artefatuais.
Uma hematoscopia realizada na região adequada da lâmina garante que as alterações, se presentes, sejam identificadas de modo seguro e confiável!
SMD em tranformação
Warning: strtotime(): It is not safe to rely on the system's timezone settings. You are *required* to use the date.timezone setting or the date_default_timezone_set() function. In case you used any of those methods and you are still getting this warning, you most likely misspelled the timezone identifier. We selected the timezone 'UTC' for now, but please set date.timezone to select your timezone. in /home/hemocla/public_html/site/blog.php on line 179
Warning: date(): It is not safe to rely on the system's timezone settings. You are *required* to use the date.timezone setting or the date_default_timezone_set() function. In case you used any of those methods and you are still getting this warning, you most likely misspelled the timezone identifier. We selected the timezone 'UTC' for now, but please set date.timezone to select your timezone. in /home/hemocla/public_html/site/blog.php on line 179
22/07/2020 |

Nem sempre o churrasco está na churrascaria!!!
Esse caso clínico comprova que nem sempre os quadros complicados hematológicos são descobertos em pacientes com sintomatologia característica. As vezes a situação vem de onde menos esperamos!!!
Paciente 23 anos, masculino, em acompanhamento com Tricologista. Sem sintomas aparentes.
Hemograma:
Eri: 2,69 / Hb: 9,0 / VG: 26,8 / VCM: 99,6 / HCM: 33,5 / CHCM: 33,6 / RDW: 16,8
Plaquetas: 125.000
Dif. Aparelho:
Neut: 29,7 / Linf: 18,2 / mono: 39,1 / eo: 0,05 / baso: 0,12 / IG: 12,3
A lâmina chega a nos assustar pela morfologia dos monócitos. São praticamente todos com tamanho aumentado e alto pleomorfismo nuclear. Também encontra-se muitos granulócitos com assincronismo de maturação, além de blastos.
O diferencial manual:
Blasto: 13 / promonócito: 2 / monócito: 29 / mielócito: 2 / metamielocito: 2 / bastonete: 5 / segmentado: 27 / linfócito: 18 / linfócito reativo: 2
VEJA AS FOTOS!
As observações do laudo:
- Presença de vários monócitos anômalos, com tamanho aumentado e intenso pleomorfismo nuclear.
- Presença de assincronismo maturativo na linhagem neutrofílica.
- Blastos de tamanho grande, moderada relação N/C, núcleo com cromatina frouxa, nucléolos evidentes, citoplasma levemente basofílico, alguns com intensa granulação.
- Presença de 4 eritroblastos em 100 células contadas.
- Policromasia moderada
Um caso que assusta pela quantidade de blastos, que, em uma coloração ruim ou com algum analista inseguro, poderia passar batido, e o diagnóstico ser negligenciado. Quando alguma coisa parece estranha na lâmina, ela é estranha!
Esses sinais de displasia levam a pensar em uma Síndrome Mielo Displásica, e essa quantidade de blastos faz pensar em uma SMD em transformação para Leucemia Mielóide Aguda, provavelmente m4 (que é uma SMD), ou m5, pensando na quantidade e morfologia de monócitos.
A mielodisplasia tem essa característica. Assincronismo, maturação anômala, células com morfologia esquisita, estranha aos nossos olhos. Um hemograma bem feito é o diferencial tanto no diagnóstico quanto no acompanhamento do paciente.
Veja que as observações do hemograma são objetivas. Ninguém falou sobre a anemia ou leucocitose, visto que os números já falam sobre isso!





